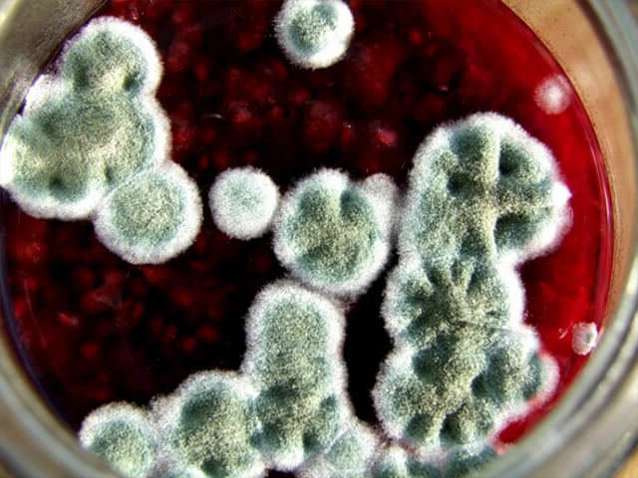
moule sur confiture

Pourquoi la confiture moisit-elle dans les bocaux et que faire, règles de couture et de stockage
La confiture est l'une des préparations les plus populaires et les plus appréciées pour l'hiver. La plupart des fruits conservent leur saveur et leurs propriétés utiles tout au long de l'hiver. Cependant, si les règles de préparation et de stockage ne sont pas respectées, le produit peut se détériorer - couvert de moisissure. Il y a plusieurs raisons pour lesquelles la confiture dans des bocaux moisit parfois, ce dont nous parlerons.
Contenu
- 1 Pourquoi la confiture dans des bocaux moisit-elle
- 2 Que faire si de la moisissure s'est formée sur la confiture?
- 3 Que se passe-t-il si vous mangez une friandise moisie?
- 4 Danger de moisissure
- 5 Comment bien refermer la confiture pour qu'elle ne moisisse pas?
- 6 Comment garder le produit de la moisissure sans l'enrouler?
- 7 Où et comment stocker au mieux les flans?
Pourquoi la confiture dans des bocaux moisit-elle
Le processus de fabrication de la confiture est simple, mais il nécessite la propreté et le respect de la recette. Des écarts dans la quantité d'ingrédients, la durée de cuisson ou les conditions de stockage entraîneront la formation de moisissures.
Les raisons:
- quantité insuffisante de sucre;
- réduction du temps de cuisson;
- utilisation de contenants contaminés, refus de stérilisation;
- scellage lâche des boîtes de conserve;
- stockage du produit dans des pièces très humides.
Non seulement les pots de confiture scellés, mais aussi les contenants non bouchés sont exposés à la moisissure. Un couvercle mal fermé est un terreau favorable pour les champignons. Ils forment un film gris clair à la surface du produit. Il gâche non seulement le goût et l'apparence, mais lorsqu'il est consommé, il peut avoir un effet négatif sur le corps humain.
Que faire si de la moisissure s'est formée sur la confiture?
Après avoir ouvert un pot de dessert, il est important de faire attention à l'état du couvercle et à la surface de la douceur. Si le haut de la confiture est moisi, le produit est probablement abîmé.

Les spores et le mycélium des champignons sont si petits qu'il est difficile de remarquer leur propagation à l'intérieur du pot, par conséquent, retirer le "capuchon" supérieur du moule ne signifie pas toujours que le produit en a été complètement retiré. Cependant, la délicatesse peut être sauvegardée si les actions correctes sont prises.
Options de récupération de dessert:
- Congelez la confiture.
Le produit est placé dans un récipient et envoyé au congélateur pendant une journée. Il est important de consommer le produit décongelé dans les 2-3 jours.
- Traitement de réchauffage.
La confiture est transférée dans une casserole et du sucre granulé est ajouté. Il y a 100 g de sucre par kilogramme de produit. Faire bouillir pendant 10 minutes.

Les méthodes sont efficaces si la confiture est moisie en surface et que les spores n'ont pas pénétré dans le sirop et les fruits. Si la conservation a changé de goût, il vaut mieux la jeter.
Que se passe-t-il si vous mangez une friandise moisie?
Manger tout produit présentant des signes de développement de moisissures peut avoir un impact négatif sur la santé humaine.Le plus souvent, il s'agit d'un trouble du système digestif ou de réactions allergiques.
De tels symptômes apparaissent si vous mangez régulièrement de la moisissure en grande quantité.
Manger quelques cuillères de friandises moisies ne provoque généralement pas d'effets secondaires chez une personne, à l'exception d'une sensation de goût désagréable dans la bouche. Un bon système immunitaire vous aide à digérer ces aliments sans conséquences.
Comme premiers soins pour l'utilisation de moisissures, vous pouvez boire du charbon actif ou vous laver l'estomac. Si l'état s'aggrave, consultez un médecin.
Danger de moisissure
Il n'est pas souhaitable de manger des aliments moisis. Malgré le fait que certains d'entre eux sont la source d'antibiotiques et ne constituent pas une menace pour la santé humaine, des champignons pathogènes peuvent également se développer dans la confiture, ce qui peut avoir un effet négatif sur les systèmes de l'organisme.
Complications:
- Maladies du tractus gastro-intestinal.
- Inflammation rénale.
- Violation de la microflore des muqueuses.
- Réactions allergiques.

Un tel produit est dangereux pour les enfants et les personnes âgées, dont les fonctions de protection du corps sont insuffisamment développées ou affaiblies. Les maladies causées par la moisissure sont difficiles à diagnostiquer, peuvent devenir chroniques et accompagner une personne tout au long de sa vie.
Comment bien refermer la confiture pour qu'elle ne moisisse pas?
La confiture conservera son goût et sa consistance si elle est réalisée selon la recette, en respectant les temps de cuisson et les proportions.
Conseils:
- Considérez le rapport entre la quantité de sucre et de fruits. Il convient de rappeler que l'ajout d'agrumes, d'épices, d'acide citrique et d'eau peut modifier la consistance et le goût de la confiture.
- Maintenez le temps de cuisson requis, vérifiez l'état du sirop et la préparation du fruit.
- Il est bon de laver le récipient et de le traiter à une température chaude pour exclure le développement de bactéries.
- Sceller hermétiquement la conservation - l'air et l'humidité sont les meilleures conditions pour le développement des bactéries.
- Évitez les températures extrêmes, la condensation.
- Conserver dans un endroit frais et sombre.

Une attention particulière doit être portée aux ustensiles de cuisine. Il vaut mieux abandonner les casseroles en aluminium ou en cuivre et utiliser des récipients émaillés ou des casseroles en acier inoxydable.
Comment garder le produit de la moisissure sans l'enrouler?
De nombreuses femmes au foyer préfèrent utiliser du capron ou des couvercles filetés, mais afin de protéger un tel produit de la croissance de moisissures, plusieurs règles doivent être suivies.
Recommandations:
- faire cuire les fruits avec beaucoup de sucre;
- augmenter le temps de cuisson;
- mettre un petit morceau de papier imbibé d'alcool sur la surface de la confiture;
- laver soigneusement le récipient avant de le remplir;
- n'utilisez pas de couvercles présentant des signes de rouille ou de dommages;
- ne préservez pas les différences de température;
- ne remplissez pas le pot à plus de 1 cm du bord;
- Garder réfrigéré.

La confiture n'est pas enroulée pour l'hiver lorsqu'elle est préparée selon la recette des «cinq minutes». Ainsi, il retient plus de nutriments, mais il est également moins stocké. Il est préférable de verser la confiture "rapide" dans des bocaux après ébullition afin que la température chaude détruit les bactéries éventuelles à l'intérieur du récipient.
Où et comment stocker au mieux les flans?
Le meilleur endroit pour conserver la conservation est considéré comme une pièce sombre avec de l'air frais et sec. Il s'agit généralement d'une cave, mais vous pouvez laisser la confiture dans la chambre ou sur le balcon.
Recommandations:
- ne pas stocker à proximité d'appareils de chauffage;
- ne laissez pas les banques être exposées à la lumière directe du soleil;
- conserver les contenants non bouchés au réfrigérateur;
- pour un usage unique, mettez une partie de la confiture dans un récipient séparé.
La durée de conservation des blancs de baies est de 9 à 12 mois. La confiture à base de baies avec graines doit être consommée dans les six mois. Il est préférable de manger une boîte ouverte dans deux semaines.

